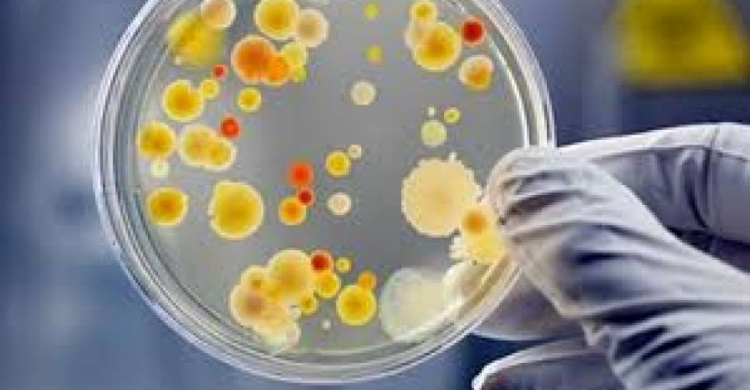

Двое взрослых и ребенок заболели ботулизмом в Донецкой области, сообщает департамент здравоохранения Донецкой облгосадминистрации.
"Оба взрослых находятся в реанимационных отделениях, сыворотки введены, состояние тяжелое", - говорится в сообщении.
В августе 2018 года Украина получила 12 доз противоботулистической сыворотки на 24 области, 3 из которых на данном этапе уже использованы жителями Донецкой области.
Ботулизм является одной из самых тяжелых инфекционных болезней, которая может привести к летальному исходу.
Ботулизма, в большинстве случаев, можно избежать, соблюдая простые пищевые правила.
Чтобы уберечься от ботулизма избегайте употребления:
• вяленой, копченой, соленой и консервированной рыбы,
• мясных и грибных консервов,
• консервов домашнего производства,
• если не уверены, что продукты хранили и / или транспортировали должным образом,
• если сомневаетесь в качестве продуктов.